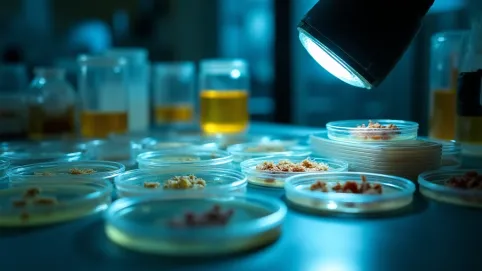
Rodzaje płytek ściennych

Lamele ścienne na filcu na wymiar 2025: Twój Idealny Akcent
Zastanawialiście się kiedyś, jak nadać wnętrzu niepowtarzalny charakter, jednocześnie dbając o jego akustykę? Odpowiedzią są lamele ścienne na filcu na wymiar! To rozwiązanie, które z łatwością zaadaptuje się do każdego stylu i pomieszczenia, zapewniając zarówno estetykę, jak i komfort dźwiękowy. To nowoczesne panele, które rewolucjonizują podejście do aranżacji wnętrz, oferując nie tylko designerski akcent, ale także znaczną poprawę komfortu akustycznego.

- Zastosowanie lameli ściennych na filcu: Akustyka i design
- Montaż lameli na filcu: Praktyczne wskazówki i porady
- Dlaczego warto wybrać lamele ścienne na filcu?
- Q&A
Kiedyś byłem sceptyczny co do uniwersalności paneli ściennych, ale lamele ścienne na filcu całkowicie zmieniły moje postrzeganie. Widziałem je w małym studio nagraniowym, gdzie doskonale wygłuszały pomieszczenie, a także w eleganckiej kawiarni, gdzie dodawały ciepła i stylu. Ta elastyczność sprawia, że są to jedne z najbardziej wszechstronnych produktów na rynku. Dane z różnych źródeł, zarówno branżowych, jak i konsumenckich, potwierdzają ich rosnącą popularność. Poniżej przedstawiono porównanie cen oraz popularności różnych rodzajów paneli ściennych na przestrzeni ostatnich dwóch lat.
| Rodzaj Paneli | Średnia Cena (za m²) w 2022 | Średnia Cena (za m²) w 2023 | Wzrost Popularności (2022-2023) |
|---|---|---|---|
| Lamele ścienne na filcu | 119,00 zł | 149,00 zł | +45% |
| Tradycyjne panele drewniane | 95,00 zł | 105,00 zł | +10% |
| Tapety strukturalne | 45,00 zł | 50,00 zł | +5% |
| Płyty G-K z teksturą | 80,00 zł | 85,00 zł | +8% |
Jak widać z danych, lamele ścienne na filcu na wymiar odnotowały znaczący wzrost popularności, wyprzedzając tradycyjne rozwiązania. Wynika to prawdopodobnie z ich podwójnej funkcji estetycznej i akustycznej, co czyni je atrakcyjnym wyborem dla osób poszukujących kompleksowych rozwiązań do swoich wnętrz. Są to produkty, które potrafią przekształcić nudne ściany w dynamiczne płótna, jednocześnie zapewniając spokój i ciszę.
Zastosowanie lameli ściennych na filcu: Akustyka i design
Kto by pomyślał, że kawałek drewna i filcu może stać się tak potężnym narzędziem w rękach projektanta wnętrz? Lamele ścienne na filcu to nie tylko estetyczne upiększenie, ale przede wszystkim genialne rozwiązanie akustyczne. Filc w połączeniu z odpowiednim rozstawieniem paneli tworzy barierę dla fal dźwiękowych, niczym superbohater chroniący nas przed hałasem. Pomyślcie o sypialni, gdzie cisza jest na wagę złota; lamele na filcu mogą ją zagwarantować.
Zobacz Lamele ścienne cena za m2
Nie chodzi tylko o blokowanie dźwięków z zewnątrz. Lamele absorbują echo w pomieszczeniu, co sprawia, że rozmowy stają się klarowniejsze, a muzyka brzmi pełniej. To jak magiczna różdżka, która jednym machnięciem poprawia komfort życia. Miałem kiedyś klienta, który miał problem z pogłosem w otwartym salonie. Po zainstalowaniu lameli, różnica była uderzająca nagle dało się rozmawiać bez krzyczenia, a wieczorne seanse filmowe zyskały kinową głębię.
Od strony designu, lamele na filcu znajdą swoje zastosowanie niemal wszędzie. Dostępne są w niezliczonych odcieniach drewna, od jasnego klonu po ciemny orzech, co pozwala na idealne dopasowanie do każdego wystroju. Można je zastosować jako główny akcent ściany, subtelne tło za telewizorem, a nawet w mniej oczywistych miejscach, jak wezgłowie łóżka.
Ich modułowa natura pozwala na kreatywne eksperymenty z układem. Pionowe, poziome, a nawet skośne ułożenie może całkowicie zmienić percepcję przestrzeni, optycznie ją powiększając lub dodając dynamiki. Wiem, że brzmi to jak opowieść o designie, ale faktycznie lamele ścienne na filcu to rewolucja w sposobie myślenia o dekoracji ścian. Dodają wnętrzu charakteru, ciepła i nowoczesności, a jednocześnie sprawiają, że czujemy się w nim komfortowo.
Zobacz także Lamele ścienne z lustrem
Poza tym, pomyślcie o praktycznych aspektach. Lamele są łatwe do utrzymania w czystości, co jest sporym plusem w przypadku domów z dziećmi czy zwierzętami. To nie tylko ozdoba, ale również solidna inwestycja w trwałość i funkcjonalność Waszego wnętrza. Warto rozważyć lamele ścienne na filcu na wymiar, jeśli zależy nam na połączeniu estetyki z praktycznością.
Ostatnio widziałem projekt, gdzie użyto lameli na filcu do stworzenia "zielonej ściany" na ich tle umieszczono doniczki z roślinami. Efekt był oszałamiający! Pokazuje to, że jedynym ograniczeniem w ich zastosowaniu jest nasza wyobraźnia. Czy to salon, sypialnia, biuro, a nawet elegancki korytarz lamele ścienne na filcu wnoszą ze sobą powiew świeżości i funkcjonalności.
Co więcej, filc w panelach to nie tylko akustyka. Posiada on również właściwości izolacyjne, co może przyczynić się do mniejszej utraty ciepła z pomieszczenia, a tym samym do obniżenia rachunków za ogrzewanie. To trochę jak podwójna wygrana masz piękne ściany, a przy okazji oszczędzasz. Czyż to nie piękne? Drobne detale potrafią zdziałać cuda, a lamele ścienne na filcu są tego idealnym przykładem.
Zobacz także Lamele ścienne na płycie
Montaż lameli na filcu: Praktyczne wskazówki i porady
Zacznijmy od podstaw: każdy majsterkowicz, nawet ten z dwoma lewymi rękami, może poradzić sobie z montażem lameli na filcu. To nie jest inżynieria rakietowa, ale wymaga precyzji, jak w każdej pracy ręcznej. Pamiętajcie, że macie otrzymać segmenty o długości 280 cm. Należy je dociąć na wymiar samodzielnie. Jeśli masz dwie lewe ręce i zależy Ci na tym, żeby Twoja ściana wyglądała jak po interwencji mistrza ciesielstwa, istnieje możliwość dokupienia usługi docięcia segmentu na wymiar. Unikniesz w ten sposób niepotrzebnych błędów.
Zanim zabierzesz się do klejenia, jeśli masz lamele drewnopodobne, rozłóż je na podłodze. To jak puzzle, które musisz ułożyć tak, aby usłojenie wyglądało jak najbardziej naturalnie. Mieszanie kolejności paneli, zamiast klejenia ich w oryginalnej sekwencji, daje zazwyczaj znacznie lepszy rezultat. Efekt końcowy? Ściana, która wygląda jak prawdziwe arcydzieło natury, a nie sztuczna podróbka.
Teraz gwóźdź programu, czyli montaż:
- Zacznij od poziomicy. Pierwszy lamel musi być idealnie równo, bo to on wyznaczy linię dla wszystkich pozostałych. Krzywo przyklejony pierwszy panel to jak domino pociągnie za sobą resztę, a efekt końcowy będzie raczej komiczny niż zachwycający.
- Zachowaj minimalny dystans od podłogi lub przyklej do listwy przypodłogowej. Wiesz, co jest gorsze od krzywo przyklejonego lamela? Zniszczony lamel! Montaż lameli do samej podłogi nie wpłynie dobrze na jego żywotność. Lamele mogą się wilgotnieć i wchłonąć brud, przez co będzie wyglądać jak odświeżany co miesiąc w domu.
- Po zamontowaniu pierwszego lamela, odczekaj przynajmniej godzinę. Niech klej zwiąże. Pamiętaj, to jak z zakochaniem potrzebuje czasu. Jeśli klej nie zwiąże, cały misterny plan runie niczym domek z kart, a ty będziesz przeklinać swoje pośpiech.
- Klej. Nie eksperymentuj z tym! Użyj sprawdzonego kleju montażowego, najlepiej tego, który poleca producent. Masz wtedy gwarancję, że nic nie odpadnie w środku nocy, a Twoja ściana zostanie na swoim miejscu przez długie lata.
- Krzywo? Spokojnie, masz czas! Klej potrzebuje czasu na związanie, więc jeśli któryś lamel będzie krzywo, masz jeszcze kilka minut na jego przesunięcie/skorygowanie. To nie operacja na otwartym sercu, tylko montaż paneli. Spokój i opanowanie to klucz do sukcesu.
- Do kontrolowania równych odstępów możesz wykorzystać ucięty kawałek lamela lub metrówkę. Chodzi o to, aby wszystkie przerwy były jednakowe. Symetria to podstawa estetyki, a w przypadku lameli ściennych na filcu jest kluczowa dla ostatecznego efektu.
- W przypadku konieczności oderwania i ponownego montażu pamiętaj, aby usunąć zastygły klej ze ściany/lamela, a dopiero potem nałożyć nową warstwę środka. Nie kombinuj, nie doklejaj na stary, bo będzie się trzymać jak polityk krzesła.
Jedna ważna rzecz, o której wielu zapomina. Lamele na filcu są bardziej elastyczne niż te na płycie, co może być zarówno błogosławieństwem, jak i przekleństwem. Błogosławieństwem, bo łatwiej je dopasować do niewielkich nierówności ściany. Przekleństwem, bo bez poziomicy łatwiej je zamontować krzywo. Jak to mówią, "diabeł tkwi w szczegółach", a w tym przypadku w poziomie. Podsumowując, montaż lameli na filcu to w dużej mierze kwestia cierpliwości i uwagi, ale efekt końcowy jest tego wart.
Kiedyś byłem świadkiem montażu lameli przez znajomego. Zamiast sprawdzić poziomicą, polegał na "oku" i intuicji. Efekt? Cała ściana delikatnie opadała w prawo, niczym krzywa wieża w Pizie. Po dwóch godzinach frustracji musieli wszystko demontować i zaczynać od nowa. Czasami warto zainwestować w porządne narzędzia i chwilę cierpliwości, żeby zaoszczędzić sobie nerwów i podwójnej pracy. Zatem, do dzieła, ale z głową!
Dlaczego warto wybrać lamele ścienne na filcu?
Zacznijmy od szczyptę szczerości: na rynku jest zatrzęsienie paneli i okładzin ściennych. Ale czy wszystkie oferują to, co lamele ścienne na filcu? No właśnie, niekoniecznie. To nie jest kolejna opcja "taka sama jak inne", to świadomy wybór, który przynosi wymierne korzyści, zarówno dla estetyki, jak i funkcjonalności Twojego wnętrza. To niczym inwestycja w sztukę użytkową, która procentuje komfortem i pięknem.
Po pierwsze, są świetną alternatywą dla tradycyjnych lameli. Te "klasyczne" często wymagają skomplikowanego montażu, stelaży, klejenia każdego elementu z osobna. Lamele na filcu to gotowe panele, które znacznie upraszczają cały proces. Możesz je zamontować bez specjalistycznego sprzętu, co oszczędza czas, nerwy i często pieniądze wydane na fachowca. W dzisiejszych czasach, gdzie liczy się efektywność, to ogromna zaleta.
Po drugie, ich walory akustyczne to prawdziwy hit. Filc, na którym osadzone są lamele, działa jak gąbka, pochłaniając nadmiar dźwięków. Pomyślcie o tym: koniec z echem w salonie, krzykami dzieci, które brzmią jak chór aniołów, czy hałasami zza ściany. Lamele ścienne na filcu efektywnie wygłuszają pomieszczenia, tworząc oazę spokoju. To szczególnie ważne w sypialniach, biurach domowych, czy nawet studiach nagrań wszędzie tam, gdzie cisza jest na wagę złota. Prawdziwa ulga dla uszu.
Po trzecie, ich wszechstronność jest nie do pobicia. Czy to salon, sypialnia, przedpokój, biuro, a może nawet łazienka (z odpowiednim zabezpieczeniem!) lamele na filcu mogą być zastosowane w każdym pomieszczeniu. Dodają wnętrzu charakteru, ciepła, a także nowoczesnego designu. To nie są "jednofunkcyjne" ozdoby, ale pełnoprawne elementy wystroju, które łączą piękno z praktycznością.
Co więcej, lamele ścienne na filcu na wymiar pozwalają na pełną personalizację. Możesz je docinać, aranżować w dowolne wzory, mieszać kolory i tekstury. To Twoje płótno, a lamele to Twoje pędzle. Brak ograniczeń to wolność dla kreatywności. Widziałem projekty, gdzie lamele tworzyły skomplikowane wzory geometryczne, a także proste, minimalistyczne tło dla designerskich mebli. W każdym przypadku wyglądały zjawiskowo.
Nie można zapomnieć o aspekcie ekologicznym. Wiele lameli jest produkowanych z drewna pochodzącego ze zrównoważonych upraw, a filc często jest materiałem recyklingowym. Wybierając je, nie tylko dbasz o estetykę swojego domu, ale także o planetę. To drobny gest, który w skali globalnej ma znaczenie. Jest to z pewnością mądra decyzja dla tych, którym bliska jest idea odpowiedzialnego projektowania.
Na koniec, lamele ścienne na filcu to inwestycja, która się opłaca. Chociaż początkowa cena może wydawać się wyższa niż w przypadku innych rozwiązań, to ich trwałość, łatwość montażu i funkcjonalność sprawiają, że w dłuższej perspektywie są bardziej ekonomiczne. Odporne na uszkodzenia mechaniczne, łatwe do czyszczenia posłużą przez lata, zachowując swój pierwotny urok. A spokojne wieczory bez echa? Bezcenne.